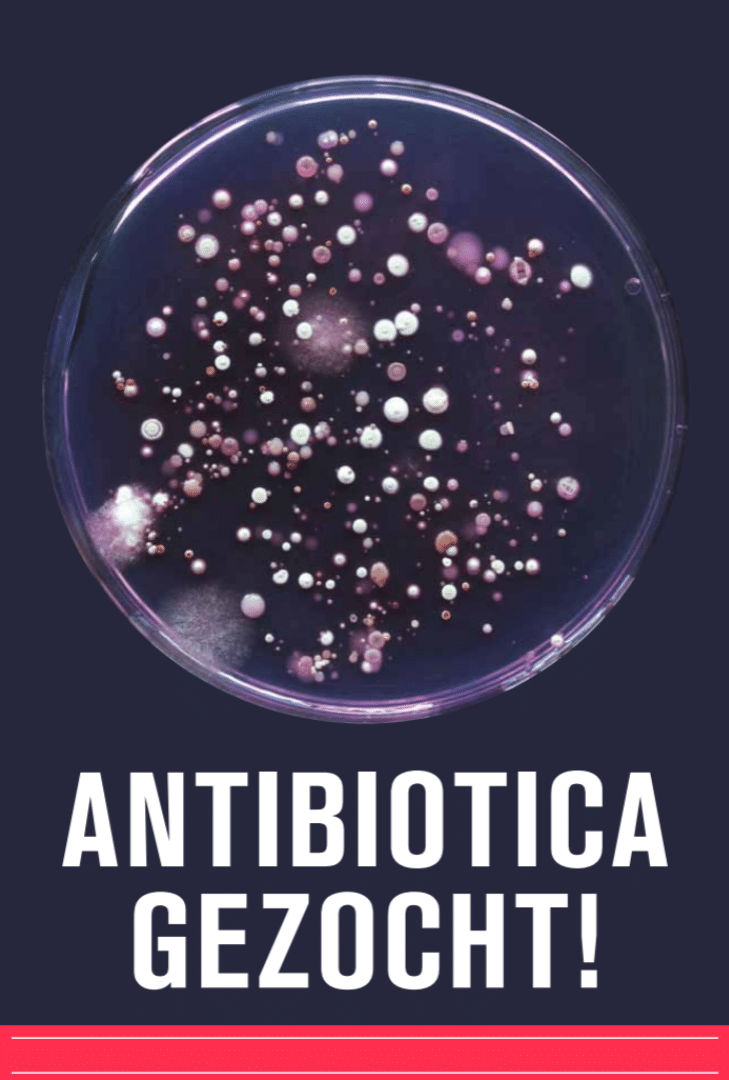

Lesmateriaal
Antibiotica gezocht!
In deze les nemen leerlingen een grondmonster en laten bacteriën uit hun grondmonster groeien op een agarplaat. Ze determineren en selecteren actinomyceten en testen deze actinomyceten op antibioticaproductie. Ze onderzoeken of er tussen de grondbacteriën van hun monsters bacteriën zitten die antibiotica produceren.
Dit is een project van Universiteit Leiden. Zijn er antibioticaproducerende actinomyceten gevonden? Dan kunnen de actinomyceten opgestuurd worden naar de onderzoeksgroep van de Universiteit Leiden voor verder onderzoek.